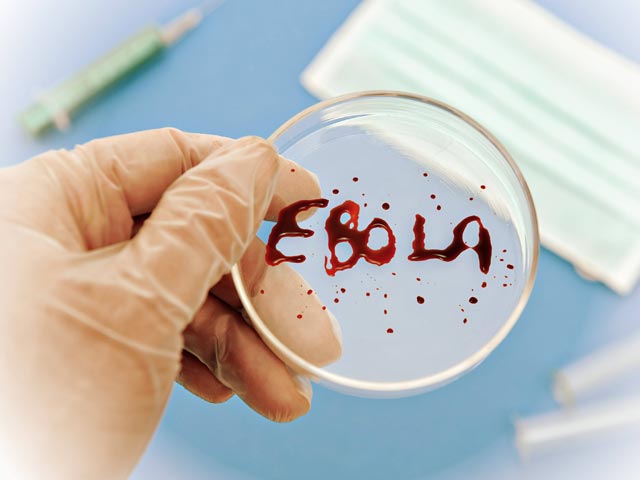

Лихорадкой Эбола заразился норвежец и медсестра из Испании
Лихорадка Эбола по-прежнему терроризирует жителей Африки, при этом инфекцию все чаще обнаруживают у волонтеров и миссионеров, которые приезжают в африканские страны бороться с болезнью. Так, "Врачи без границ" сообщили, что их сотрудник родом из Норвегии заразился вирусом в Сьерра-Леоне. Кроме того, в Мадриде инфицирована медсестра, которая лечила больного Эболой миссионера.
Норвежский специалист, имя которого не называется, был помещен в карантин в минувшее воскресенье, 5 октября, по подозрению в заражении смертельным вирусом. Позднее тест дал положительный результат, передает ТАСС.
Как сообщает организация "Врачи без границ", пациента доставят в Норвегию, где он будет проходить лечение. В ближайшее время он будет перевезен в госпиталь в Осло.
Что касается медсестры из Испании, то, как сообщает Reuters, тест на смертельную инфекцию также показал положительный результат. Ее случай стал первым заражением лихорадкой в европейской стране. Заметим, что медсестра входила в команду, которая лечила миссионера Мануэля Гарсия-Вьехо, умершего от лихорадки Эбола 26 сентября.
До сих пор все пациенты, больные Эболой, заражались ей в Африке. В Испании это третий житель страны, подхвативший опасный вирус, передает El Pais. К сожалению, двое испанских граждан не смогли побороть болезнь. По словам испанских медиков, в настоящий момент под наблюдением находятся 30 работников из сферы здравоохранения, которые приняли участие в лечение зараженных Эболой пациентов.
Стоит подчеркнуть, что врачи в последнее время представляют обнадеживающие данные. Во всяком случае, многие пациенты излечиваются. Так, французские и немецкие врачи в минувшую субботу рапортовали об излечении больных лихорадкой Эбола.
Они поведали, что французская медсестра выздоровела после курса лечения экспериментальным препаратом. Она также входит в организацию "Врачи без границ". В Германии врачи рассказали о выздоровлении пациента из Сенегала, которого на протяжении пяти недель лечили в больнице Гамбурга.
Добавим, что в США получил предварительное одобрение Управления по вопросам качества продовольствия и медикаментов экспериментальный медицинский препарат, разработанный американской фармацевтической компанией Chimerix. Лекарство называется Brincidofovir. Для проверки его безопасности требуются дополнительные испытания, но в экстренных случаях его уже можно использовать для лечения людей. Отметим, что до этого американцам удалось вылечить несколько человек с помощью экспериментальной вакцины ZMapp, созданным компаниями LeafBio и Defyrus Inc.
Унесшая почти 3,5 тысячи жизней лиходарка Эбола, по мнению ученых, к 24 октября может поразить Великобританию, Францию и Бельгию. Специалисты, проанализировавшие маршрут распространения вируса и информацию авиакомпаний о перелетах, оценивают шансы в 75%, 50% и 40% соответственно. Также под угрозой оказались Испания и Швейцария - по 14%. Стоит добавить, что к этим странам может присоединиться и США, где недавно был госпитализирован "техасский пациент", который прилетел в США через Европу из Западной Африки.